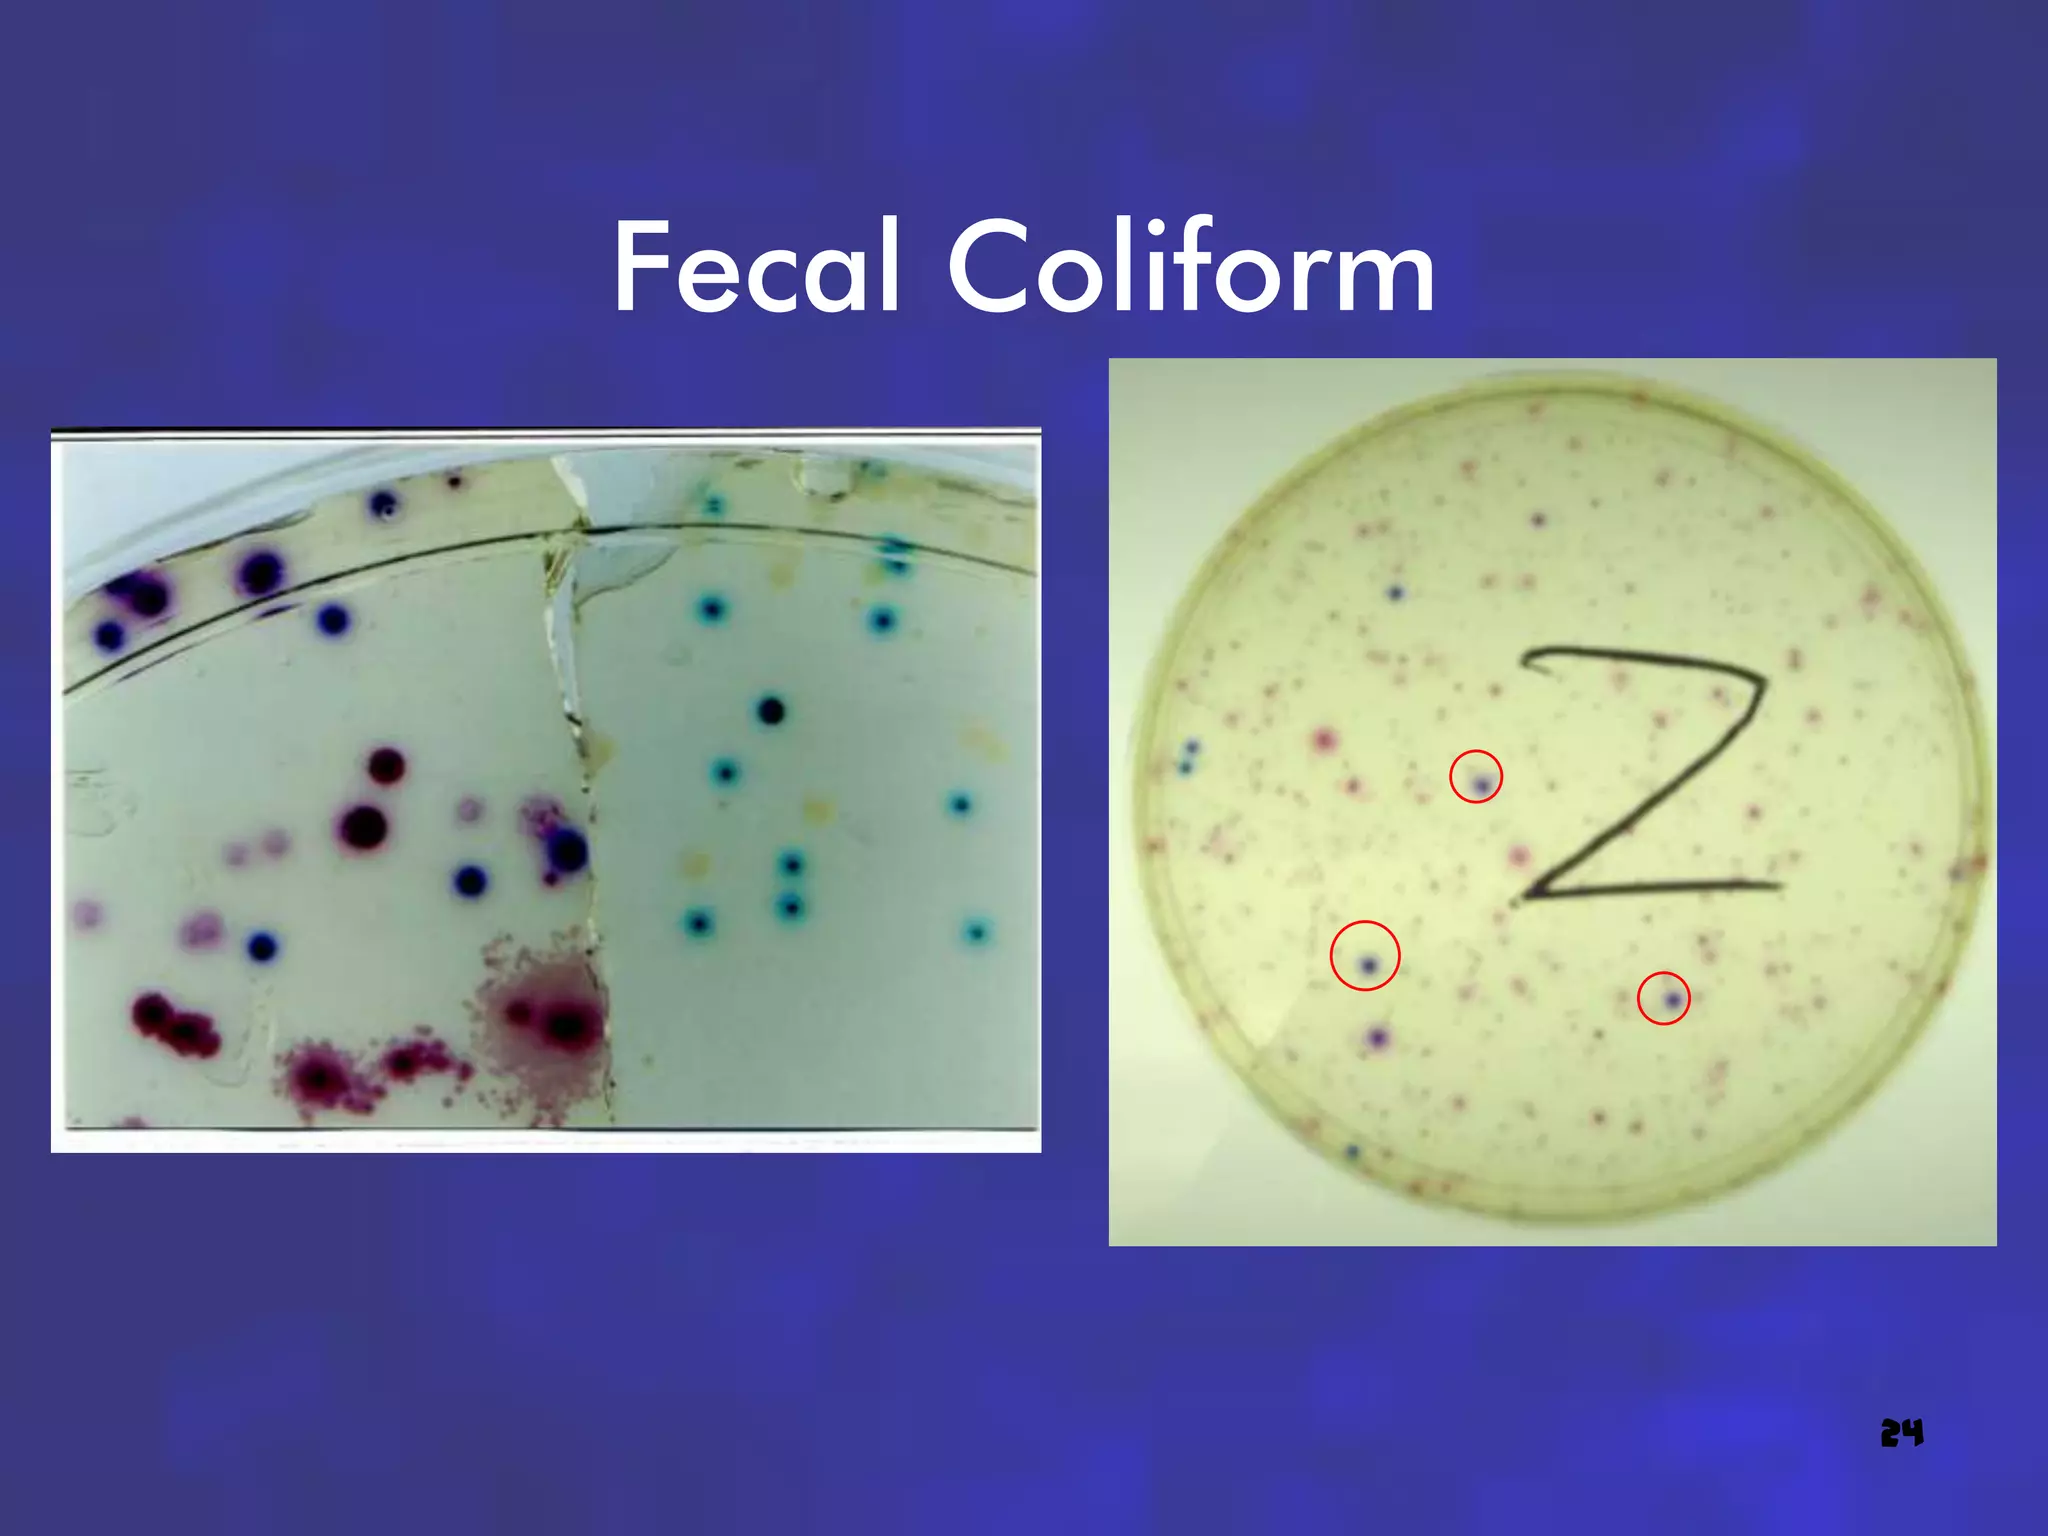
Fecal Coliform




                 24

The document summarizes a 2010 study of the Shell Creek and Loseke-Taylor Creek watersheds conducted by researchers from the Lower Platte North Natural Resources District. Water quality was assessed at 6 sites along the creeks through tests of dissolved oxygen, fecal coliform, pH, BOD, temperature, phosphates, nitrates, turbidity, and total solids. Results were used to calculate a Water Quality Index for each site. Overall, water quality was found to be medium to poor, with elevated levels of fecal coliform and total solids observed. Flow rates also varied significantly between sites and sampling dates.